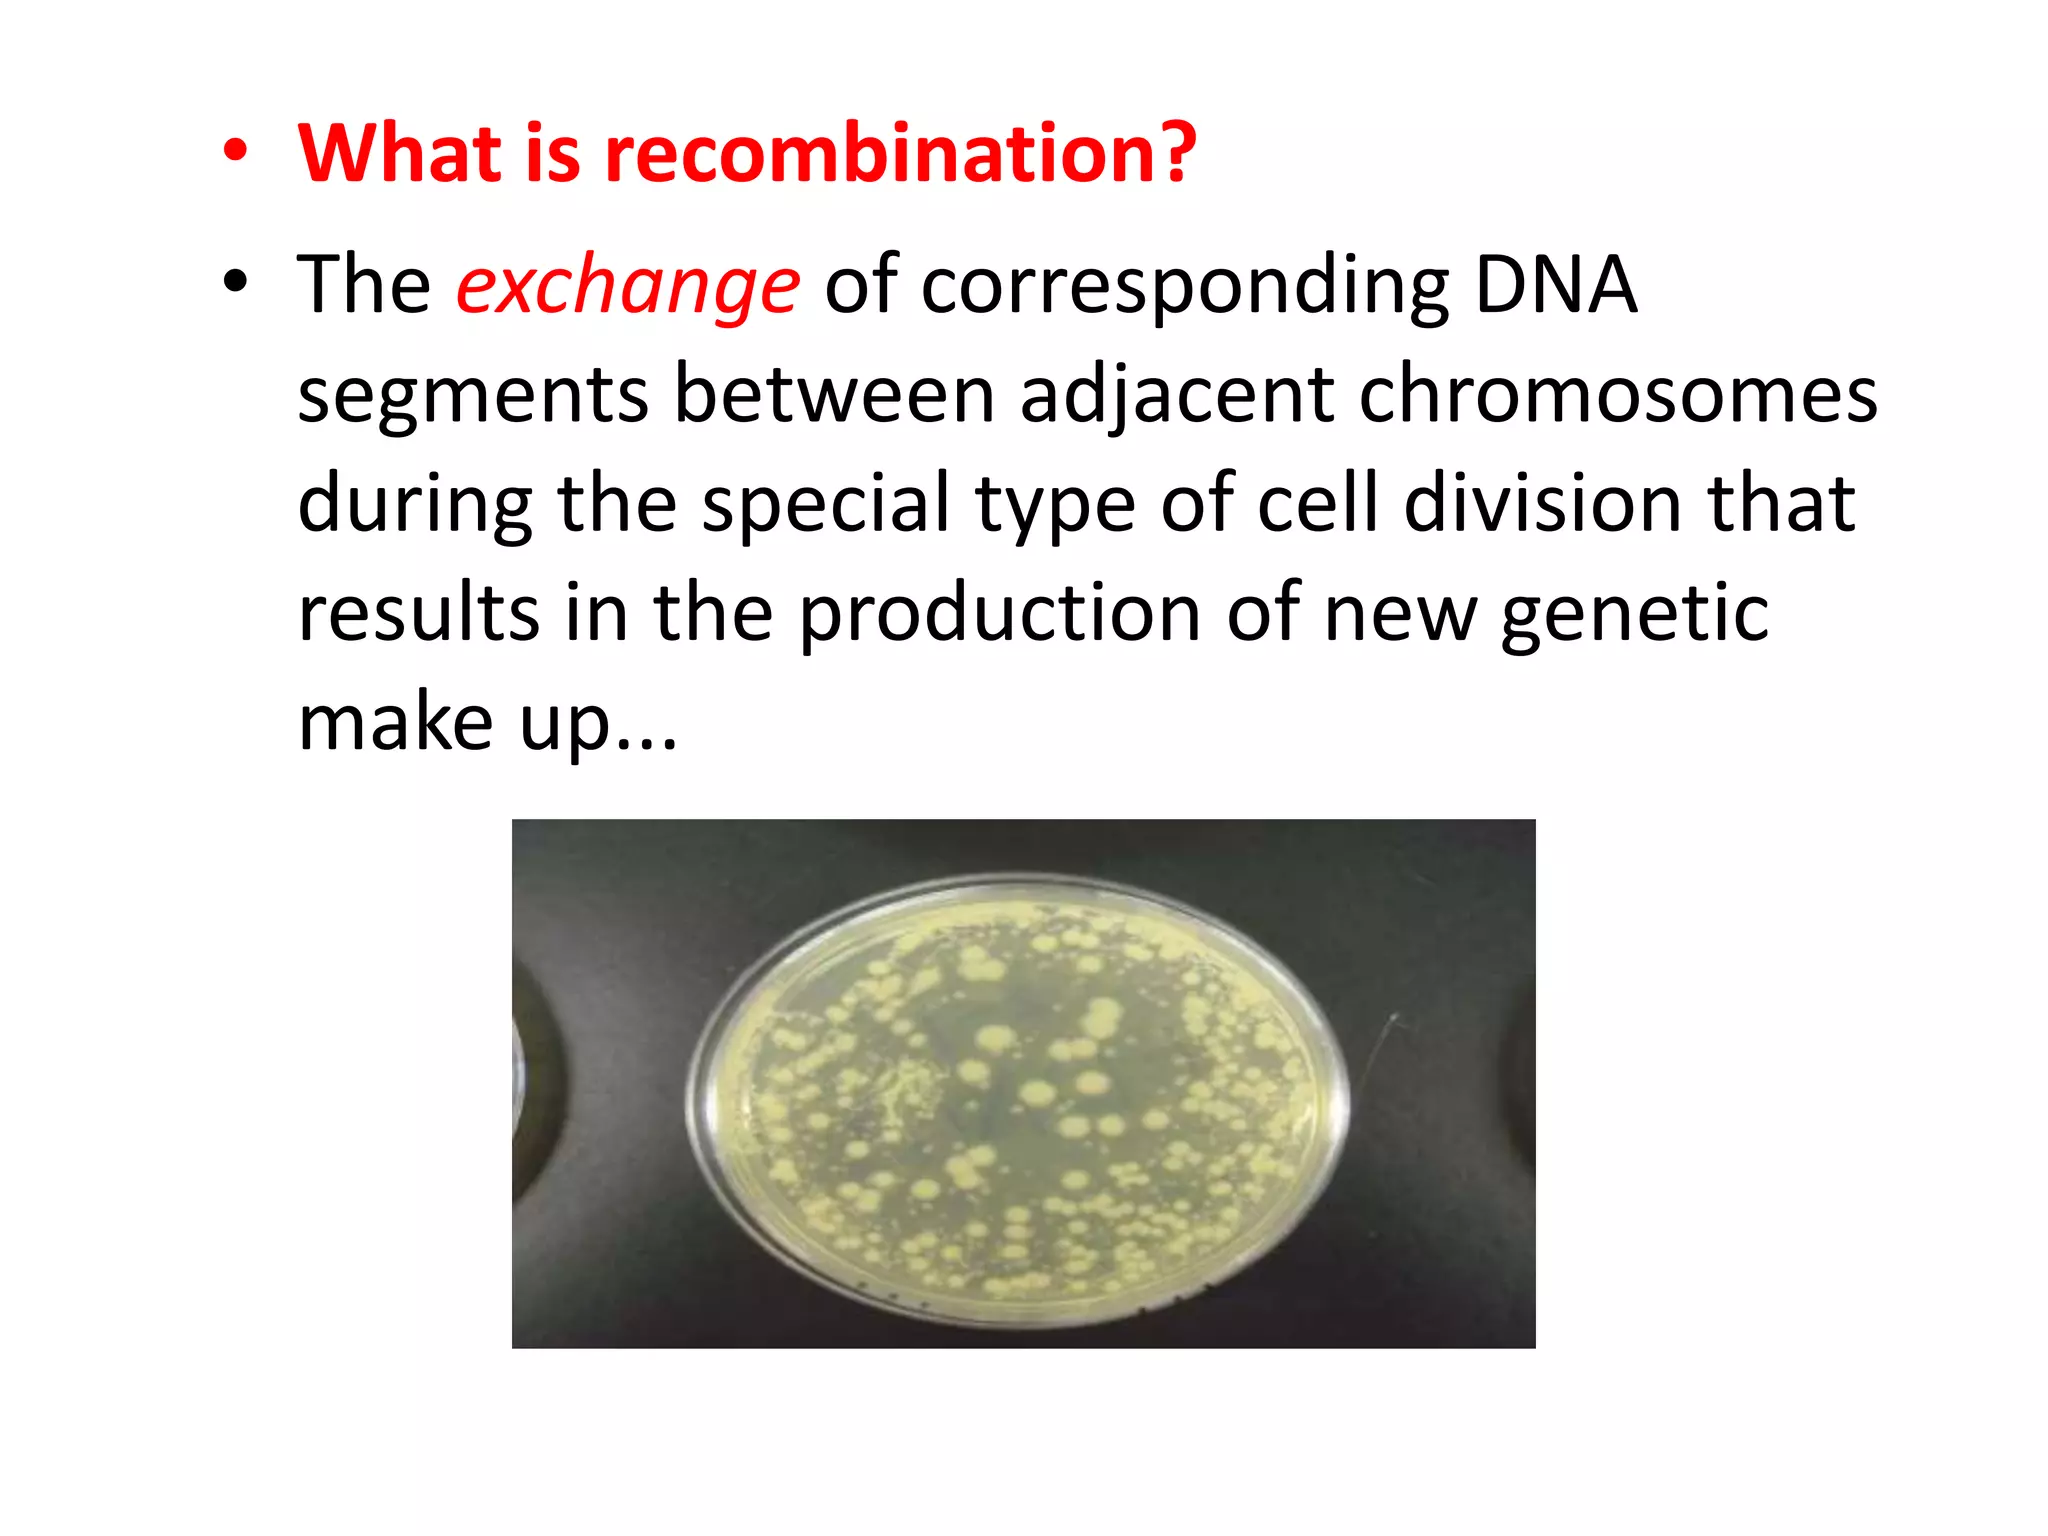
• What is recombination?
• The exchange of corresponding DNA
segments between adjacent chromosomes
during the special type of cell division that
results in the production of new genetic
make up...

Recombinant DNA technology involves extracting DNA from different sources and joining them together, such as combining animal and bacterial DNA. It is used in genetic engineering to artificially recombine DNA from different organisms. Key applications include producing the enzymes chymosin for cheese making and insulin for diabetes treatment, as well as blood clotting factor VIII and vaccines. Recombinant DNA technology is important for basic research and has led to safer, more effective and abundant medical products.